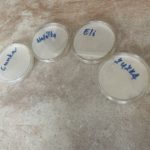
foto2 131
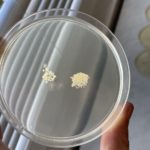
foto5 111

Vedecký kuriér Biológia je veľmi zaujímavou aktivitou realizovanou v rámci projektu Európska noc výskumníkov, ktorého cieľom je podporiť vedu a výskum na školách. V tomto školskom roku sme v rámci projektu na hodinách biológie v laboratóriu pozorovali svoju genetickú informáciu DNA a vlastné baktérie. Zatiaľ čo deviataci a ôsmaci skúmali vyizolovanú DNA vo svojom roztoku, šiestaci vytvorili kultiváciu vlastných baktérií z rúk. Experimenty sa podarili a pohľad to bol veru zaujímavý!
- Úvod
- Škola
- Vzdelávanie
- Školský klub
- Centrum voľného času
- Stravovanie
- Letný tábor
- Kontakt